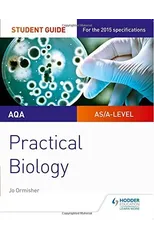
AQA A-level Biology Student Guide

Biology
Filtro

GCSE Biology AQA Grade 8-9 Targeted Exam Practice Workbook (includes answers)
CGP Books
Paperback
Publicada:
2021

Pearson REVISE AQA GCSE Biology (Foundation) Revision Guide - for 2026, 2027 exams
Pauline Lowrie
Multiple-com
Publicada:
2017

James Loeb and the History of Psychiatric Medicine
Proceedings of the Third James Loeb Biennial Conference, Munich and Murnau 4–6 June 2023
Jeffrey Henderson
Hardcover
Publicada:
2025